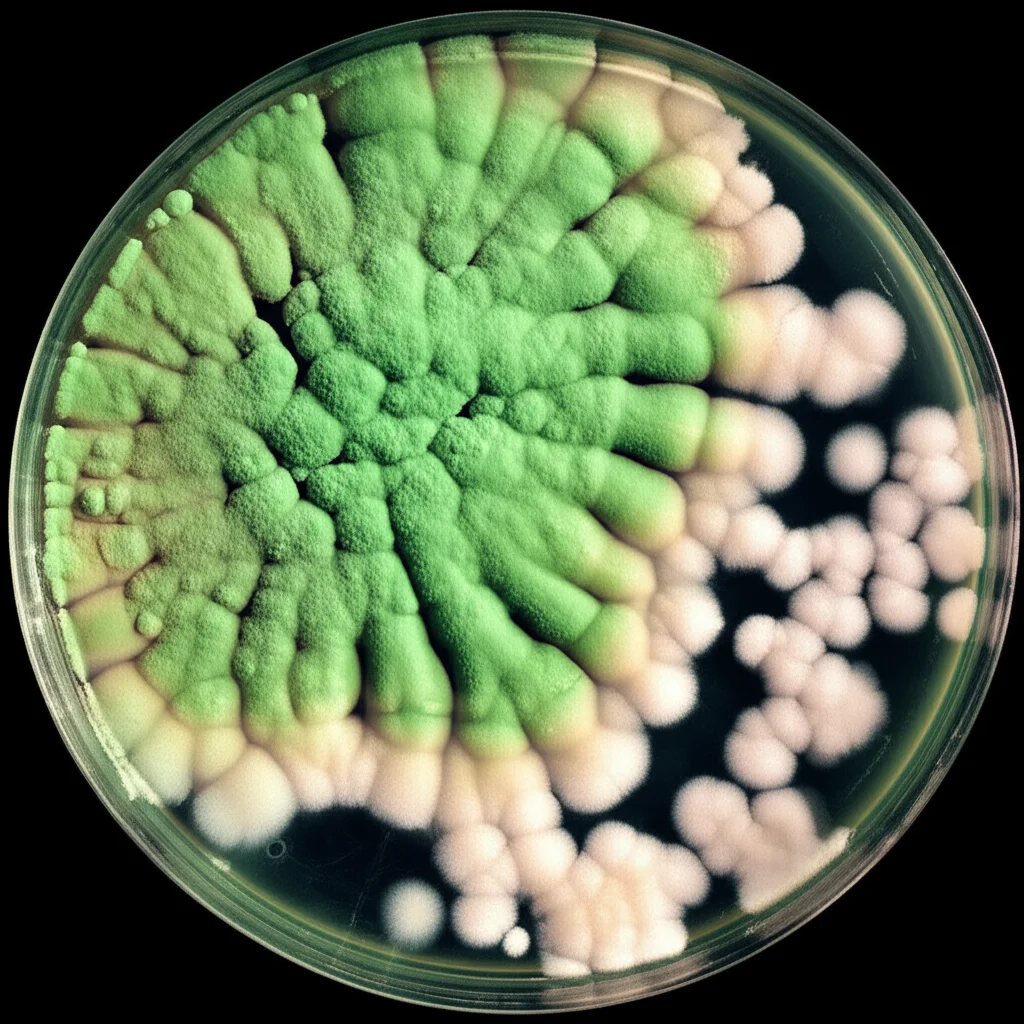
Macro foto, 90mm lens, del fungo Trichoderma asperellum (verde) che cresce aggressivamente e sovrasta le colonie del fungo Fusarium oxysporum (bianco-rosato) in una piastra di Petri da laboratorio, alta definizione, messa a fuoco precisa, illuminazione controllata da laboratorio.

Trichoderma Asperellum: L’Alleato Segreto dei Tuoi Pomodori Contro la Terribile Fusariosi!
Ciao a tutti gli appassionati di orto e agricoltura! Oggi voglio parlarvi di una sfida che molti di noi conoscono fin troppo bene: la fusariosi del pomodoro. Sapete, quella malattia subdola causata da un fungo cattivello chiamato Fusarium oxysporum f. sp. lycopersici, che può trasformare le nostre amate piante di pomodoro, rigogliose e piene di promesse, in un triste spettacolo di appassimento e perdita di raccolto. È un nemico tenace, capace di sopravvivere nel terreno per anni e di causare danni economici enormi, a volte portando via fino all’80% del raccolto! Ma non disperate, perché la natura stessa ci offre degli alleati sorprendenti, e oggi vi racconto la storia di uno di questi eroi microscopici: il Trichoderma asperellum.
Il Nemico Invisibile: Capiamo la Fusariosi
Immaginate questo fungo, il Fusarium, come un pirata del suolo. Si avvicina furtivamente alle radici delle nostre piante di pomodoro, le invade e si fa strada nei tessuti vascolari, quelli che la pianta usa per trasportare acqua e nutrienti. È come se bloccasse le tubature! Il risultato? La pianta inizia ad appassire, partendo dalle foglie più vecchie, fino a soccombere completamente. E la cosa peggiore è che questo “pirata” lascia dietro di sé delle “spore dormienti” (clamidospore) che possono rimanere nel terreno per un decennio, pronte a colpire di nuovo. Controllarlo con i metodi tradizionali, spesso basati sulla chimica, può essere difficile e non sempre sostenibile per l’ambiente o per le nostre tasche.
L’Eroe Inaspettato: Ecco a Voi Trichoderma Asperellum!
Ma ecco che entra in scena il nostro protagonista: Trichoderma asperellum. Non fatevi ingannare dal nome complicato, pensate a lui come a un fungo “buono”, un vero e proprio guardiano del suolo. Si trova comunemente nel terreno e ha delle capacità incredibili: non solo può migliorare la disponibilità di nutrienti per le piante e promuoverne la crescita, ma è anche un formidabile antagonista dei funghi patogeni come il nostro Fusarium. È un agente di biocontrollo, il che significa che usiamo un organismo vivente per combatterne un altro, in modo del tutto naturale ed ecologico. Fantastico, vero? Diversi studi, incluso quello che vi sto raccontando, hanno dimostrato che T. asperellum può ridurre significativamente la malattia della fusariosi nei pomodori. Ma come fa esattamente?
La Scienza Dietro la Magia: Come Funziona il Biocontrollo
Qui le cose si fanno affascinanti. Ho seguito da vicino (virtualmente, s’intende!) uno studio specifico che ha messo alla prova questo fungo benefico. I ricercatori hanno fatto due tipi di test:
- In vitro (in laboratorio): Hanno messo T. asperellum e F. oxysporum “faccia a faccia” su una piastra di coltura. Il risultato? Dopo soli 6 giorni, T. asperellum aveva ridotto la crescita del patogeno del 90%! Praticamente lo ha sopraffatto.
- In vivo (sulle piante vere): Hanno coltivato piante di pomodoro in vaso, alcune trattate con T. asperellum, altre no, e poi le hanno infettate con Fusarium (tranne un gruppo di controllo sano, ovviamente). Hanno monitorato la progressione della malattia usando un indice chiamato AUDPC (Area Under the Disease Progress Curve), che in pratica misura quanto gravemente e rapidamente si diffonde la malattia. Ebbene, le piante trattate con T. asperellum prima dell’infezione hanno mostrato un valore AUDPC molto più basso (242.84) rispetto a quelle infettate senza protezione (AUDPC 351.34). Meno malattia, piante più sane!
Ma la cosa più interessante non è solo la lotta diretta. T. asperellum fa qualcosa di ancora più intelligente: “addestra” la pianta di pomodoro a difendersi meglio!
L’Arma Segreta: L’Induzione dei Geni di Difesa
Pensate al sistema immunitario delle piante. Proprio come noi, anche le piante hanno meccanismi di difesa. T. asperellum, quando colonizza le radici (senza danneggiare la pianta, anzi!), agisce come un segnale di allarme precoce. Prepara la pianta a reagire più velocemente e più efficacemente in caso di attacco da parte di un vero patogeno. Questo fenomeno si chiama Resistenza Sistemica Indotta (ISR).
Nello studio, hanno analizzato l’espressione di alcuni geni specifici della pianta di pomodoro legati alla difesa (come PAL3, PR10, PRS, CH4, PR4) usando una tecnica chiamata qRT-PCR. Cosa hanno scoperto?
- Nelle piante trattate solo con T. asperellum, molti di questi geni di difesa erano super attivati (espressione aumentata di 10, 170, 4, 45 e 50 volte rispettivamente per PAL3, PR10, PRS, CH4 e PR4 rispetto al controllo!). Era come se la pianta fosse in stato di allerta potenziato.
- Nelle piante trattate con T. asperellum e poi infettate con Fusarium, l’espressione dei geni PR10 e PR4 era particolarmente alta (60 e 40 volte). Questo suggerisce che T. asperellum “prepara” la pianta, e quando arriva il patogeno, la risposta difensiva, specialmente tramite questi geni PR (Pathogenesis-Related), è pronta ed efficace.
- Nelle piante infettate solo con Fusarium, si attivava principalmente il gene PR10 (55 volte), ma la risposta complessiva sembrava meno orchestrata e, come visto dai dati sulla malattia, meno efficace nel proteggere la pianta.
Questi geni PR sono come dei soldati specializzati che la pianta produce per combattere gli invasori. Ad esempio, alcuni producono enzimi (come chitinasi e glucanasi, menzionati anche nello studio come potenziali armi di Trichoderma stesso) che possono degradare la parete cellulare dei funghi patogeni. Altri geni, come PAL, sono coinvolti nella produzione di composti difensivi. Il fatto che T. asperellum stimoli l’attivazione di questi geni è la chiave della sua efficacia come agente di biocontrollo.

Perché Tutto Questo è Importante? Verso un’Agricoltura più Verde
Questi risultati sono entusiasmanti! Ci dicono che Trichoderma asperellum non è solo un “fungicida naturale” che attacca direttamente il patogeno, ma è anche un vero e proprio “vaccino” per le piante, che ne potenzia le difese interne. Questo apre la strada a strategie di gestione delle malattie più sostenibili ed ecologiche. Usare agenti di biocontrollo come T. asperellum significa:
- Ridurre la dipendenza dai fungicidi chimici, con benefici per l’ambiente, la salute del suolo e la nostra salute.
- Offrire agli agricoltori uno strumento efficace ed economico per proteggere i loro raccolti.
- Promuovere un’agricoltura che lavora *con* la natura, invece che contro di essa.
La prossima volta che gusterete un pomodoro succoso, pensate a questi incredibili aiutanti microscopici che potrebbero aver contribuito a proteggerlo! La ricerca nel campo del biocontrollo è in continua evoluzione e ci promette un futuro in cui potremo coltivare cibo sano in modo più rispettoso del nostro pianeta. E io non vedo l’ora di scoprire quali altre meraviglie la natura ha in serbo per noi!
Fonte: Springer
